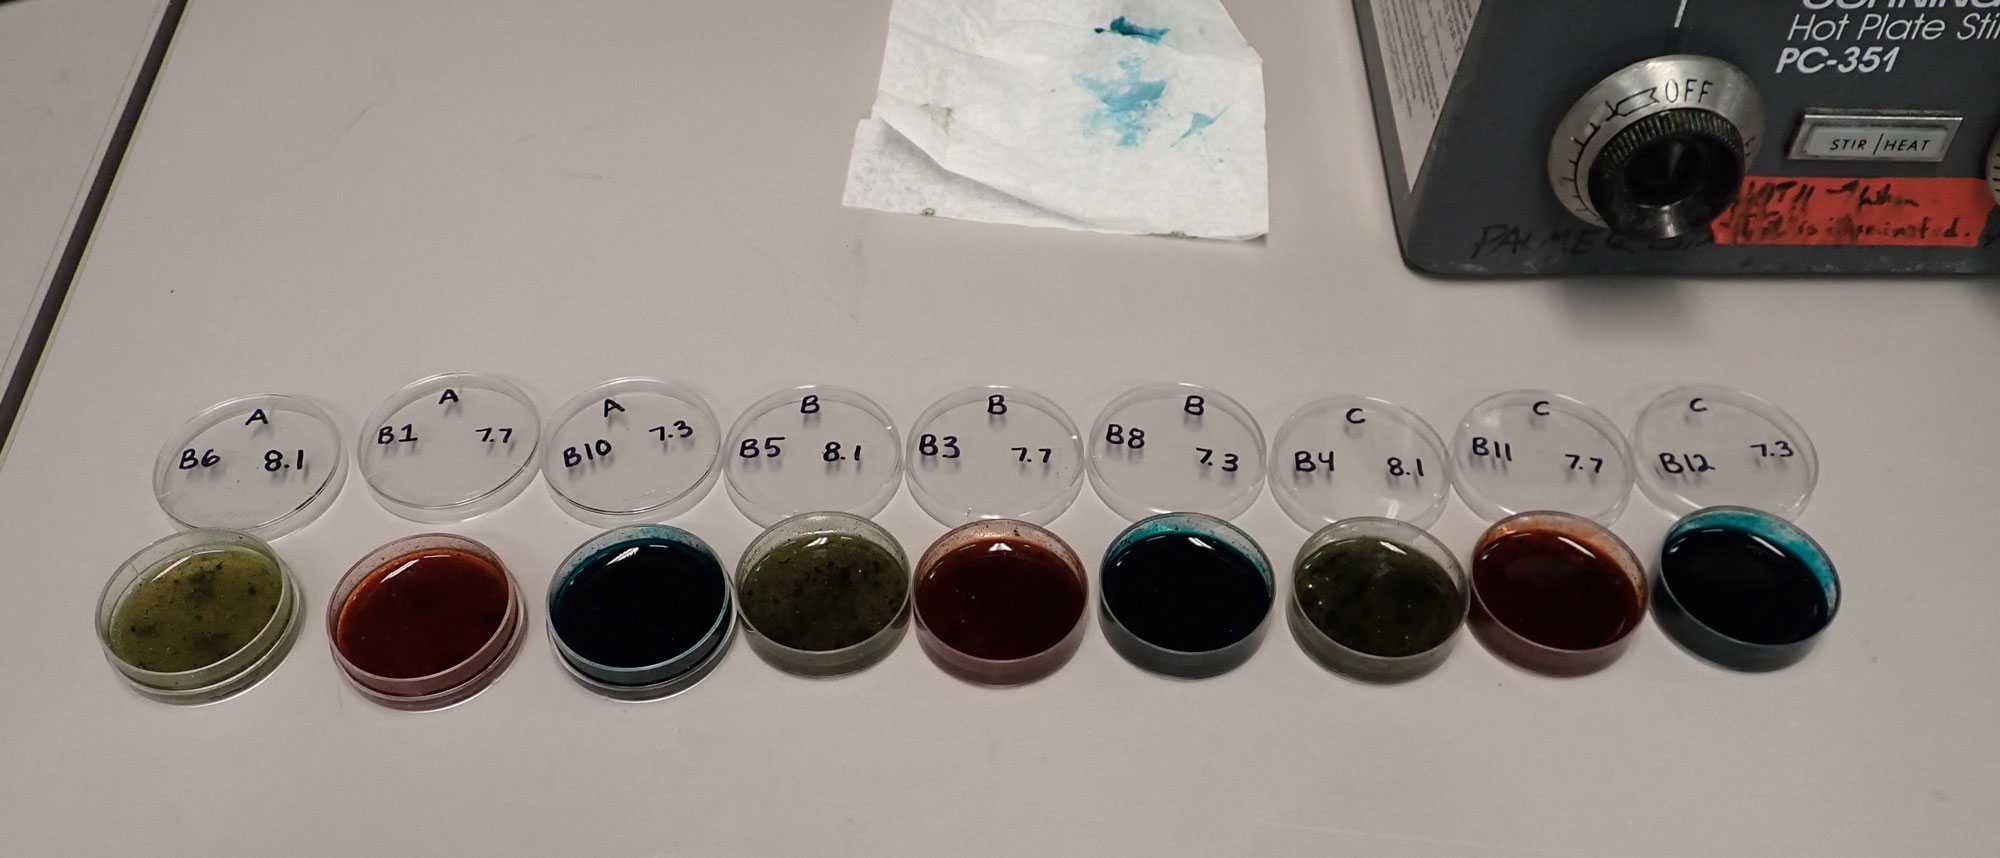

A large amount of focus has been given to our main experiment this season. While this experiment is very important, I think its unfair that some of our other projects haven’t been given the attention they so rightly deserve. Well, not today! In this blog post, I will tell you all about my two palatability experiments I ran this season.
We have mentioned before that amphipods typically do not eat Desmarestia menziesii, the brown alga they are commonly found on here in the Western Antarctic Peninsula. This is true while the alga is alive but not when its dead. D. menziesii, like many other seaweeds in this region, produce chemical defenses that make it taste bad to hungry fish and crustaceans. However, these defenses slowly deteriorate when the alga dies and allows amphipods to feast on yummy seaweed. The time it takes for a seaweed to become palatable after it dies is dependent on the amount of chemical defenses it produces.
In contrast to D. menziesii, there is a red alga called Palmaria decipiens that does not make any chemical defenses. It is classified as a palatable alga to the amphipods because they will eat it while it is still alive.
We know that D. menziesii tastes bad and P. decipiens tastes good to amphipods, but ocean acidification could change how bad or how good the algae tastes. Lowering the pH of seawater increases the amount of carbon dioxide in the water which could be beneficial for photosynthesis, but the lower pH could also stress the seaweed.
A set of side experiments I ran this season focused on trying to figure out if ocean acidification will impact the palatability of D. menziesii, an unpalatable alga, and P. decipiens, a palatable alga.
For the first half of my experiment, I focused on Palmaria. I took eight individual algae and split each one into three parts. These parts were split between each of the pH treatments where they stayed for 18 days. After 18 days, I cored two small disks from each of the pieces. Next, I tied a colored thread through each disk to represent which treatment it came from and weighed the disks. I then set up paired bottles with a set of disks from the same alga in each bottle. One of the bottles remained empty while the other had amphipods. I allowed the amphipods to munch on the disks for a couple of days then weighed the disks again to see if one of the treatments was eaten more. The results of this experiment showed that amphipods prefer algae that was kept in our ambient or middle pH treatment over the algae kept in our low pH treatment. You can see what these disks looked like in the image below.

The experiment for my unpalatable alga was a little more intense. I took D. menziesii that was kept in our pH treatments from last season and froze them. At UAB, I made extracts of the chemical defenses. We took these extracts with us to Palmer Station this year. Here, I took some of the extract and mixed it with powder from a palatable alga to create an extract infused powder that I used to make little algal pies with food coloring. Look at how cute they are below!
Similar to the Palmaria experiment, I took cores of the pies and paired them with control bottles. The control bottles help me determine how much the weight of the pies changed from being submerged in water. I once again let the amphipods chow down and weighed the pies at the end of the experiment. The weight change of the control pies and the weight change of the experimental pies let me know how much of the pies were actually eaten by the amphipods. I compared these weight changes between the treatments and found that pies made from the ambient extracts were eaten more compared to the middle and lower pH treatments.
These results are very exciting to me. I now get to sit down and figure out possible reasons to why I saw these results in my experiments, but that can wait till a later date. Right now, I am prepping for the take down of our main experiment in two days! Stay tuned for more updates on that project.
A haiku for your consideration:
Tiny nibble sounds
Radiate from our bottles
As the pods fine dine